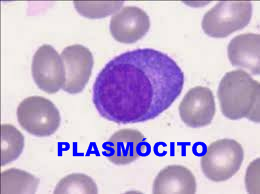
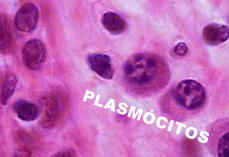

Professor Titular da USP
Covid-19
INTRODUÇÃO: Uma resposta imunológica é a reação do sistema imunológico a um antígeno. O processo de defesa do corpo através do sistema imunológico é chamado de resposta imune.
Prof. Dr. Sérgio N. M. Lima.
Profa. Dra. Izabel Yoko Ito.
As respostas imunes sempre estão associadas a reações inflamatórias que foram uma grande preocupação para a saúde da população. Hoje, em virtude da Pandemia do Corona vírus, a doença ganhou, pela sua importância, um destaque em todo o mundo científico.
Os estudos da maioria das doenças, destes tempos antigos são relacionados ao processo inflamatório. Que o médico romano Celso anos 50dc, estudou profundamente a inflamação e, descreveu com precisão os sinais da inflamação, que são válidos até hoje: Edema, calor, rubor, dor e perda da função.
Este estudo tem por objetivo descrever, os complexos mecanismos envolvidos no processo inflamatório.
O Sistema de Defesa do organismo é complexo, mas perfeito em seus mecanismos.
Nossas pesquisas e estudos, na Faculdade de Odontologia e Farmácia da USP, foram mais relacionado a boca, contudo seus resultados se aplicam, na Biologia da Resposta Imunológica tem todo o corpo humano.
Para entendermos estas complexas reações estudaremos o Processo Inflamatório.
As reações inflamatórias, são mecanismos altamente diferenciados, as respostas do processo de defesa do organismo podem ser natas, isso é inespecífica, ou específicas.
A reposta inespecífica, são mediadas principalmente pelos neutrófilos, que têm a capacidade de fagocitarem e destruírem os patógenos (Ag).
NEUTRÓFILOS: São células sanguíneas leucocitárias que fazem parte essencial do sistema inato. Pertencem a classe dos granulócitos, junto aos eosinófilos e basófilos, pois apresentam núcleos lobulares e contêm grânulos citoplasmáticos. Estão envolvidos na defesa contra bactérias, fungos, vírus e partículas.


Na primeira foto vemos uma lâmina de células sanguíneas, onde podemos observar dois neutrófilos e alguns glóbulos vermelhos. Na segunda foto, o esquema de uma célula fagocitando uma bactéria.
O SISTEMA IMUNOLÓGICO, é o guardião primordial de nossa saúde. O conhecimento de seu funcionamento é de suma importância, para que a ciência possa desenvolver mecanismos, vacinas, antibióticos, para a proteção de todos. No presente momento assumiu enorme importância seu conhecimento, devido à pandemia do Covid-19.
Como o próprio nome diz, Sistema em nosso corpo, é um grupo de órgãos que juntos executam determinadas tarefas, no caso o sistema imunológico, faz a–+ DEFESA DE NOSSO ORGANISMO. Nós mamíferos, temos vários Sistemas em nosso organismo, Sistema nervoso, circulatório, digestivo, respiratório entre outros. Neste trabalho abordaremos o Sistema Imunológico, procurando estudar as respostas Biológicas envolvidas em seus numerosos mecanismos.
Como veremos o sistema imunológico, é composto por uma complexa rede de células especializadas, de tecidos e de órgãos, unidos em um mesmo mecanismo, para nos defender dos patógenos.
Considerações:
Os leucócitos são as principais células de defesa do organismo. São formadas nos tecidos hematopoiéticos, e histodifeciam-se, formando todos os tipos de células que estão no sangue. Os eritrócitos ou glóbulos vermelhos são os predominantes. A série branca são: mastócitos, neutrófilos, eosinófilos, basófilos, monócitos, linfócitos T e linfócitos B.

Nesta lâmina vemos um infiltrado inflamatório ativo. Nesta lâmina, corada com H/E, pode-se ao microscópio, observar as células de defesa presente, que participam dos mecanismos de defesa do hospedeiro.
AS CÉLULAS BRANCAS DE DEFESA SÃO:

Esta lâmina apresenta exemplos das céluas brancas de defesa do organismo.

Importante salientar que os neutrófilos pertencem ao Sistema Imune Inato. Sistema imune inato, sistema imunitário inato ou imunidade inata é o conjunto de formas de imunidade que nasce com o indivíduo, sem necessidade de introdução de substâncias ou estruturas exteriores ao organismo.


Eosinófilos. A primeira imagem é de uma célula eosinofílica de uma lâmina corada com H/E. A segunda imagem do Google, é da imagem feita por micróspio eletrônico de varredura M/E, de um eosinófilo.
Eosinófilos são um tipo de glóbulo branco do sangue que desempenha um papel importante na resposta do organismo a reações alérgicas, asma e infecção por parasitas. Essas células participam da imunidade protetora contra certos parasitas, mas também contribuem para a inflamação que ocorre em distúrbios alérgicos.
3. BASÓFILO: Possui forma esférica e núcleo irregular em forma de trevo. Tem tamanho de aproximadamente 10-15 µm (micrometros). Seu núcleo geralmente é segmentado ou bilobulado, raramente com três ou mais lóbulos. Seu citoplasma é levemente basofílico (cor azul) e quase sempre ofuscado pelos vários grânulos grosseiros corados de roxo. Os granulos estão dispostos irregularmente cobrindo também o núcleo.

Basófilo.
Os basófilos possuem em sua estrutura inúmeros grânulos, que, em situações de inflamação ou alergia, por exemplo, liberam heparina e histamina para combater o antígeno. Granulócito basófilo é um tipo de leucócito que se fixa com corantes básicos. Representa menos de 1% dos leucócitos.
São granulócitos derivados de progenitores na medula óssea, onde amadurecem, constituindo menos de 1% dos leucócitos do sangue periférico. Embora não estejam normalmente presentes nos tecidos, podem ser recrutados para sítios inflamatórios, em conjunto com eosinófilos. Os grânulos presentes nos basófilos apresentam mediadores similares aos dos mastócitos. Os basófilos também expressam Fc, ligam IgE (anticorpo) e são ativados por complexos IgE + antígeno, podendo contribuir para as reações de hipersensibilidade imediata (tipo I).
AS CÉLULAS BRANCAS DE DEFESA MONOMORFONUCLEARES SÃO:

Esta é uma fotografia de uma lâmina corada com H/E em um microscópio ótico. Normalmente, o núcleo do linfócito T, ocupa grande parte de seu citoplasma.

Esta é uma imagem do Google com técnicas especiais e M/E. Esta imagem é extraordinária, pois mostra os antígenos, bactérias, vírus, e partículas, em contato com a célula de defesa.
Os linfócitos T ou células T pertencem a um grupo de glóbulos brancos do sangue e são os principais efectores da chamada imunidade celular. São originados a partir de células hematopoiéticas pluripotentes na medula óssea (assim como os demais leucócitos) e sofrem posterior maturação no timo. Nesse órgão, os linfócitos T adquirem os receptores de membrana específicos CD4 ou CD8.
O linfócito T auxiliar, CD4+, tem a função de coordenar a função de defesa imunológica contra vírus, bactérias e fungos, principalmente através da produção e liberação de citocinas e interleucinas. São capazes de estimular a resposta imune humoral através de ligação direta com linfócitos B, ativados através da expressão de MHC de classe II carregado com antígeno, que interagem com o TCR.
O linfócito T citotóxico, CD8+, tem como função principal a eliminação de células infectadas por parasitas intracelulares, nominalmente os vírus. Dentro dessas células, a produção de proteínas não pertencentes ao indivíduo são em parte processadas pelo proteassoma, produzindo peptídeos exógenos, que, após envio ao Retículo Endoplasmático Rugoso com auxílio da proteína TAP, são expostos na parte de fora da célula. Ao reconhecer um antígeno como não próprio, o linfócito citotóxico libera grânulos contendo perforinas e granzimas que causam dano direto às células adjacentes.

Esta é uma imagem do micróspio eletrônico de varredura, do Google, de um laboratório de Berlim, mostrando os vírus corona 19, posicionando para a entrada em uma célula de defesa, célula esta que é um Linfócito T. Segundo os cientistas, o paciene desta imagem está imunizado, já teve contacto com o vírus. Desta maneira os vírus, não conseguirão penatrar na célula e se multiplicarem, contaminando o paciente. O objetivo da vacina, é imunir todos, de maneira que os antígenos (Ag) vírus, ao penetrarem no organismo, encontrem anticorpos (Ig), que os impedirão de se muntiplicarem nas células do organismo humano.
LINFÓCITO B.


A primeira fotografia de uma lâmina corada com H/E em um microscópio ótico. A segunda é com técnicas especiais, no M/E, mostrando os pontos de fixação da parede celular. Importante que a diferenciação entre os linfócitos T e B, é feita por reações imunogênicas,
Linfócito B ou célula B é um tipo de linfócito que constitui o sistema imune. Ele tem um importante papel na imunidade humoral e é um essencial componente do Sistema imune adaptativo. A principal função das células B é a produção de anticorpos (Ig) contra antígenos (Ag). Após sua ativação os linfócitos B podem sofrer diferenciação em plasmócitos ou células B de memória. O “B” em sua nomenclatura remete à bursa, um divertículo da cavidade cloacal das aves. Embora inexistente em mamíferos, nesses os tecidos linfóides associados à bursa podem ser encontrados nas paredes do intestino, apêndice, amígdalas, baço e outros órgãos. Ao passo que os linfócitos B desenvolvem-se nesses tecidos, os chamados linfócitos T desenvolvem-se usualmente no timo.
São os Linfócitos B, que em presença dos antígenos (Ag), irão se transformar em plasmócitos e produzir as Imunoglobulinas (Ig), que serão os anticorpos específicos nas reações imunológicas nos hospedeiros. Ou seja, Ig X Ag.
Estas células têm a capacidade de produzir anticorpos contra substâncias e organismos estranhos que casualmente invadam o tecido conjuntivo. Ricas em ergastoplasma, são células anti-inflamatórias que se originam na diferenciação dos linfócitos B que chegam até os tecidos conjuntivos através do sangue.
MASTÓCITO:

O mastócito é uma célula do tecido conjuntivo, originada de células do tecido hematopoiético. Contem em seu interior grande quantidade de grânulos de Histamina (Substância envolvida nos processos de reações alérgicas) e Heparina (uma substância anticoagulante). A função mais conhecida desta célula é nas reações alérgicas. E sua ação imediata, a qualquer agressão ao tecido conjuntivo.
A principal função dos mastócitos é armazenar potentes mediadores químicos da inflamação, como heparina (anticoagulante), histamina (vasodilatador), serotonina, o fator quimiotático dos eosinófilos na anafilaxia.
Células eosinofícas, presença em função da quimiotaxia dos mastócitos, são células do Sistema Imune, responsáveis pela ação contra parasitas multicelulares e certas infecões nos vertebrados. Desenvolvem-se na medula óssea (hematopoiese) antes de migrar para o sangue periférico. Tais células são eosinofílicas (possuem “afinidade por ácido”) – normalmente transparentes, aparecem de cor vermelho-tijolo após coloração com a eosina, um corante vermelho e ácido. A coloração fica concentrada em pequenos grânulos no citoplasma celular, que contêm vários mediadores químicos, como a histamina e proteínas como a peroxidase de eosinófilos, ribonuclease (RNase), desoxirribonucleases, lipase, plasminogênio, e a proteína básica maior. Estes mediadores são liberados por um processo chamado degranulação após a ativação do eosinófilo, e são tóxicos para os tecidos do parasita e hospedeiro.
FUNÇÕES: Célula envolvida nas reações de hipersensibilidade imediata, acredita-se que também participam de processos alérgicos; produzem histamina e heparina. Não são considerados os precursores dos mastócitos pois eles têm origens diferentes. Os basófilos são ativados pela presença de estímulos como as anafilotoxinas (complementos C3a, C4a e C5a) e os complexos IgE-antigeno. A resposta dos basófilos traduz-se em dois processos complementares: desgranulação e libertação de histamina; e sintese e libertação dos produtos da cascata do ácido araquidónico: leucotrienos, tromboxanos e prostaglandinas. A sua participação no choque anafilático (sistêmico) é maior que o mastócitos, pois os basófilos são células que realmente estão presentes no sangue, e liberam os mediadores para a circulação
MACRÓFAGOS: Estas células pertencem ao tecido conjuntivo, são grandes, possuindo características morfológicas variáveis, dependendo de seu estado funcional, seu tamanho varia de 10 a 30 µm. Estas células são derivadas dos monócitos. Elas têm a capacidade de fagocitose.


A primeira imagem são 2 macrófagos, em um esfregaço corado com H/E, examinado com 1000X. A segunda é um macrófago, em terceira dimensão, com seus prolongamentos filopódios, agindo como tentáculos, para incorporar as bactérias em seu citoplasma e destruí-las. (A segunda foto é do Google)
Esta é a imagem de um macrófago ao microscópio eletrônico, mostrando todas suas características. Seus prolongamentos estão capitulando microrganismo no tecido conjuntivo. Ao serem observadas ao M/E, elas apresentam uma superfície irregular, com protrusões e prolongamentos, que caracterizam seu grande poder de fagocitose e pinocitose.
Suas funções são de extrema importância para o Sistema Imune: São “apresentadores” de Antígenos, pois vão fagocitar o Ag, digeri-lo no fagolisossoma, e liberam as Interleucina I (IL-1).
Após a produção da Interleucina, quando fagocitam bactérias e organismos invasores, dando de forma efetiva o alarme para todo Sistema Imune.
A interleucina 1 é a responsável pela febre nas infecções.
Esta citocina (IL-1) estimula os linfócitos T, até a região do processo inflamatório.
Linfócitos T (Reação Celular). Passam pelo Timo, motivo do nome. Eles identificam e matam os patógenos e células infectantes. Existem os linfócitos T de memória.

Os linfócitos T, são células do sistema imunológico e também um grupo de glóbulos brancos (leucócitos) responsáveis pela defesa do organismo contra antígenos (Ag). Sua função principal é a imunidade específica e celular, induzindo a apoptose, isto é, a destruição de células, vírus, bactérias invasoras.
Existem linfócitos T, citotóxicos (CD8), linfócito T auxiliar, linfócito natural killer (NKT), de memória (CD45) e reguladoras.
O linfócito T auxiliar, CD4, tem a função de coordenar a função de defesa imunológica contra vírus, bactérias e fungos, principalmente através da produção e liberação de citocinas e interleucinas. São capazes de estimular a resposta imune humoral através de ligação direta com linfócitos B, ativados através da expressão de MHC de classe II carregado com antígeno, que interagem com o TCR.


Os vírus são sistemas biológicos muito pequenos e simples que só conseguem replicar-se dentro de células vivas, pois não possuem metabolismo próprio.
Linfócito B,
(Reações humorais).
A principal função das células B é a produção de anticorpos contra antígenos. Após sua ativação os linfócitos B podem sofrer diferenciação em plasmócitos.
PLASMÓCITOS: Os Linfócitos B, quando expostos aos antígenos (Ag), se histodiferenciam em plasmócitos, que produzem e secretam grandes quantidades de anticorpos (Ig), que são fundamentais na destruição dos microrganismos. Os anticorpos ligam-se aos microrganismos que e tornam suscetíveis aos fagócitos e assim ativam o importante Sistema Complemento.
A célula B somente se transforma em um plasmócitos frente a um antígeno específico, durante a resposta imune primária. Estas células (plasmócitos de memória) têm uma vida longa, e estão prontas a responder a um antígeno específico, ou seja, ao mesmo antígeno, que a sensibilizou.

Esquema de um linfócito B, frente a um antígeno Ag específico, se transformando em plasmócito, que irá sintetizar um anticorpo Ig, específico para neutralizar e destruir o agente agressor.
O PROCESSO INFLAMATÓRIO:
O processo inflamatório inicia-se após romper as barreiras de proteção do organismo, geralmente represendo pelos tecidos epiteliais e as mucosas.
RESISTÊNCIA DO HOSPEDEIRO: São as forças de defesa do hospedeiro a qualquer ataque. A resistência pode ser:
1. Inespecífica.
2. Específica.
INESPECÍFICA, são representadas pelas barreiras, isto é, aquela que faz parte da estrutura de proteção. Pode ser o epitélio ou as mucosas. São barreiras de células epiteliais estratificadas e ceratinizadas ou não, é uma forma de resistência inespecífica.
Os fluídos orgânicos também protegem as mucosas, sendo barreiras inespecíficas. As células descamadas também ajudam nas barreiras.
A migração dos leucócitos, principalmente os polimorfos nucleares neutrófilos (PNN), que são os micrófagos, desempenhando um papel fundamental nesta defesa ainda inespecífica à agressão bacteriana.
VIRULÊNCIA: Dos agentes patológicos é um importante fator no desenvolvimento de uma doença. Na atualidade temos considerado muito a patogenicidade e transmissibilidade do Corona vírus.
OS PRINCIPAIS FATORES DE VIRULÊNCIA DAS BACTÉRIAS SÃO:
1. Lançando produtos tóxicos diretamente no tecido do hospedeiro.
2. Ter mecanismos capazes de ativar o sistema imunológico do hospedeiro.
A grande procura científica na atualidade, é descobrir uma vacina, que seria uma proteína, RNA modificado, ou um vírus inativado, que irá ativar o linfócito LT4, a se transformar em plasmócito, que produziria uma imunoglobulina (Ig), capaz de inativar o vírus Covid 19.
Considerações sobre substâncias que atuam, nos tecidos causando profundas alterações e destruição de células: PROTEASES DESTRUTIVAS – METABÓLICOS TÓXICOS – CITOTOXINAS CELULARES.
Alguns fatores interferem na proteção normal do hospedeiro, como certas células que produzem enzimas que quebram as moléculas protéicas de imunoglobulina (IgA e IgG).
Outras bactérias, sintetizam e eliminam enzimas e fatores quimiotáteis, que provocam a degranulação de células de defesa com degeneração celular.
MECANISMOS DE ALTERAÇÕES TECIDUAIS.
Sabe-se agora que a destruição tecidual não é um processo contínuo, mas processa-se em fases, ou períodos de destruição.
São fenômenos episódicos, existem duas fases na destruição tecidual:
1. As bactérias ou seus produtos entram em contato direto com as células e outros componentes do tecido, causando danos.
2. As substâncias bacterianas podem interagirem, especificamente com componentes do sistema de defesa do hospedeiro, desencadeando um processo inflamatório ou uma reação imunopatológica.
A INFLAMAÇÃO AGUDA E FORMAÇÃO DO EXSUDATO INFLAMATÓRIO:
As primeiras alterações que ocorrem são vasculares.
Os vasos se dilatam, as células endoteliais deixam espaços intercelulares abertos, os granulócitos e monócitos se aderem nas paredes dos vasos, encontrando caminho para o tecido conjuntivo, e migram através do epitélio juncional.
A permeabilidade vascular torna-se muito aumentada, permitindo a passagem de todos os componentes do sangue para os tecidos.
Os linfócitos B e T iniciam as alterações blásticas, depois aparecem plasmócitos no tecido.
As alterações inflamatórias que se processam até esse momento, são semelhantes ao processo que ocorre em todos tecidos do organismo.
A RESISTÊNCIA ESPECÍFICA.
A resistência específica é a mais fundamental, representada pelo SISTEMA IMUNOLÓGICO do hospedeiro, que deverá estar preparado para 3 situações importantes nessa defesa.
1. Deve estar preparado para reconhecer e dar uma resposta específica a milhões de diferentes antígenos (Ag), que ainda não tenha sido reconhecido antes pelo sistema imune. Aí está a importância de uma vacina, para todas as patogenias.
2. Deve reconhecer as moléculas já marcadas “self”.
3. Deve estar preparado para diferenciar as várias classes de microrganismos invasores, dando uma resposta de máxima eficiência, com um mínimo dano aos tecidos envolvidos.
O tecido conjuntivo normal contem: Vasos sanguíneos, linfáticos, fibroblastos, mastócitos e macrófagos.
Apesar do baixo nível de migração leucocitária ela é contínua e isto é muito importante. Todas estas células e estruturas participam do sistema de defesa do hospedeiro.
Tanto em nível local como sistêmico. As alterações teciduais ocorrem deste os primeiros momentos que o antígeno está presente.
A MICROCIRCULAÇÃO: A injúria ao tecido tem como resposta uma alteração profunda na microcirculação local. Após uma vasoconstrição imediata segue-se vaso dilatação, com aumento da circulação sanguínea, com alterações também na parede dos vasos.
A permeabilidade vascular aumenta, e o plasma e elementos figurados do sangue vão para os espaços extra vasculares onde atuarão nos processos.
Mastócitos. Distribuído por todo tecido conjuntivo principalmente situados periféricos aos vasos sanguíneos. Os mastócitos circulam na sua forma imatura, apenas amadurecendo no tecido de atuação. Eles estão presentes no intestino e nos pulmões. É a principal célula responsável pelo famoso choque anafilático local (no tecido conjuntivo).
Caracterizados por grânulos eletro-densos, que são compostos por heparina, histamina e outros mediadores do processo inflamatório.
Tem as substâncias vaso ativas mais potentes, e são importantes nas reações alérgicas, as imunoglobulinas IgE ficam aderidas a ele (mastócitos) e quando encontram com os antígenos (Ag), os mastócitos “explodem”.

Esta fotografia é de uma mastócito, no momento que é estimulado, e lança no tecido, seus produtos ativos, histamina e heparina. Fotografia do Google, laboratório iStck.
FAGÓCITOS: NEUTRÓFILOS (PMN).
Representam a primeira linha de defesa do organismo contra todas formas de injúrias aos tecidos. A função do PMN é essencial para a vida.
Movendo quimiotaticamente para lugares apropriados, fagocitando, matando e digerindo microrganismos, englobando e destruindo substâncias tóxicas, como os complexos imunes, tecidos e células destruídas.
Os grânulos dos PMN contêm lisossomos, fosfatase alcalina, lactoferrina, hidrolase ácida, proteínas catiônicas e mieloperoxidase.
Substâncias endógenas que têm quimiotactismo para PMN, produtos da ativação do complemento, quininas, prostaglandinas, linfocinas, fibrinase, colagenase, e produtos de degradação de tecidos.
Os PMN representam a primeira linha de defesa do organismo. Quando esta linha de defesa é quebrada mudanças catastróficas ocorrem nos tecidos.

MACRÓFAGOS.
Os macrófagos ingerem, matam, e digerem os microrganismos, detritos destes restos dos tecidos, células lesadas, glóbulos vermelhos alterados e proteínas.
Tem na superfície receptores para Fc das imunoglobulinas e componentes C3b do complemento.
Possui todas as organelas para a síntese proteica. Possui receptores para substâncias quimiotáticas
Os macrófagos são ativados pela ação de substâncias bacterianas (Ag), complexos imunes e linfocinas, e depois produzem a interleucina-1, que ativará os linfócitos.
Os macrófagos são células essenciais para a resposta imunológica.
Os linfócitos T e B, dependem da interleucina-1 produzida pelos macrófagos para suas respostas mitogênicas e blásticas.
Os macrófagos participam ativamente nas respostas inflamatórias crônicas dos tecidos, mas seu papel somente agora tem sido estudado. Assim, desempenham um importante papel na defesa dos tecidos, qualquer alteração deste equilíbrio leva a inflamação.
OS EFEITOS DOS ANTICORPOS INCLUEM.
1. Toxinas e outras substâncias antigênicas não tóxicas são inativadas e neutralizadas pela combinação com anticorpos específicos formando complexos imunes. Estes complexos são ingeridos por fagócitos e eliminados assim como o antígeno sozinho.
2. Anticorpos específicos combinam com as superfícies dos germens invasores, em determinados pontos, formando complexos imunes que ativam o Complemento, levando sua destruição.
3. Os anticorpos opsonizam ou cobrem os germens e outras substâncias, para que os neutrófilos e macrófagos executem a fagocitose.
Quando substâncias químicas ou estímulos físicos agridem os tecidos, estes estímulos atingem os mastócitos, que são células grandes com o citoplasma repletos de grânulos contendo principalmente histamina e também outras substâncias que uma vez liberadas no interior do tecido conjuntivo vão atuar nas células do sistema retículo endotelial (SRE).
As células do SRE formam a parede dos capilares.
Mais de 40% dos capilares em um tecido normal estão inativos, isto é, não estão conduzindo sangue. A presença da histamina no tecido, faz com que as células do SRE absorvam água, aumentando de tamanho e consequentemente haverá um aumento do diâmetro da luz dos capilares, o que propiciará um aumento significativo do fluxo sanguíneo no tecido.
Mudança de cor do tecido, a hiperemia que ocorre nesta fase faz com que a primeira alteração clínica do tecido torne-se evidente, isto é, o tecido fica rosa pálida que posteriormente, torna-se vermelha e brilhante (faze do Rubor).
A histamina presente produzirá ativação dos macrófagos (que são também células do Sistema Retículo Endotelial que evoluíram a partir dos monócitos).
Fica evidente, que os polimorfos nucleares neutrófilos, (PNN), NEUTRÓFILOS, são as células de defesa que iniciam a respostas de defesa do hospedeiro, iniciando a fagocitose, de bactérias ou substâncias que tenham desencadeado o processo inflamatório. O PNN ingere as substâncias agressoras e as digerem.
MACRÓFAGOS, também fagocitam as substâncias, podem destruir estas substâncias, ou modificá-las produzindo outras substâncias diferentes que são os superantígenos (interleucina I e II) que representam uma fase importantíssima nas reações inflamatórias, que serão as reações imunológicas que terão início na segunda fase de defesa dos processos inflamatórios que ocorrem nos tecidos.
RESISTÊNCIA ESPECÍFICA.
A resistência específica são as defesas que o hospedeiro desenvolve especificamente contra um determinado microrganismo.
Isto é, o microrganismo (antígeno), estimula o sistema imunológico do hospedeiro e este produzirá substâncias (anticorpos) e fatores que irão combater diretamente o agente agressor.
Quando as resistências inespecíficas não deram conta da defesa do hospedeiro as resistências específicas são desencadeadas.
ANTÍGENOS (Ag):
O termo antígeno ou imunógeno, significa toda espécie molecular de origem protêica, uma célula, vírus, liquido biológicos ou sintética que quando introduzida em um organismo vertebrado (chamado hospedeiro ou receptor) é capaz de produzir uma reação imune.
Antígeno (Ag) é toda substância estranha ao organismo que desencadeia a produção de anticorpos (Ig). O sistema imunológico responde ao antígeno produzindo uma substância chamada anticorpo, e este vai atuar contra o antígeno. Ativando seus linfócitos que por sua vez se multiplicam e mandam sinais (citocinas) que ativam outras respostas imunes adequadas ao invasor. Pode ser a molécula de uma bactéria, vírus, fungos, helminto, toxinas ou mesmo componentes inofensivos como alimentos, pólen ou células de outro organismo que sejam identificados como uma ameaça a ser destruída.
Por exemplo para o diagnóstico da Covid 19, o teste usado é feito buscando a presença do antígeno para o coronavirus. É feito um exame imunológico, que avalia a proteína viral do SARS-Cov-2 no organismo. O resultado poderá diagnosticar infecção viral atual, mas não detectar os anticorpos adquiridos, isto seria a imunidade. Os testes hoje disponíveis utilizam metodologia de imunocromatografia ou imunoensaio fluorescente.
O teste de antígeno desta maneira é muito importante, por ser rápido e indolor, detectando a proteína do nucleocapsídeo viral, se o resultado for positivo, significa infecção viral ativa. Paciente está doente. Existem outros testes, mas do antígeno é o mais rápido.

Este é um esquema do vírus, SARS-Cov-2 tirado do Planeta biologia (Google).
Os antígenos podem ser classificados em completos e incompleto.
Completos são macromoléculas capazes de induzir a resposta imune e depois reagir com as (Ig) imunoglobulinas ou com as células sensibilizadas.
Os antígenos incompletos, ou haptenos, são micromoléculas, que somente induz a resposta imune se estiver acoplado a uma macromolécula (proteína), aí sim, vai funcionar como indução e reação, capacidade esta chamada de função antigênica.
MACRÓFAGO.
Este elemento representa a primeira célula imunocompetente do organismo. O antígeno fagocitado pelo macrófago, sendo desconhecido, estranho ao organismo (not self), sofrem a digestão intra-celular e então serão destruídos se não forem antígenos, se forem sofrerão uma marcação transformando em SUPER-ANTÍGENOS que irão atuar nos linfócitos B e linfócitos T.
Assim as substâncias para funcionarem como antígenos completos devem ser: “not self”, sofrer ação enzimática dos macrófagos, serem solúveis nos líquidos orgânicos e terem um elevado peso molecular.
A primeira imagem é de um macrófago ao microscópio ótico, mostrando seu citoplasma e seu núcleo lobulado. A segunda, mostra um macrófago, com seus pseudópodes capturando uma substância antigênica, para ser fagocitada. No caso trata-se de uma bactéria talvez uma espiroqueta. Após ser introduzidas nas organelas digestivas do fagócito, ela será identificada: Se for SElF, será eliminada pelo Sistema Imunológico, pois já existirá um antígeno Ig, específico para sua eliminação.
Se, contudo, for Not Self, o mastócito liberará um Super Antígeno, que irá acionar todo o Sistema Imune, para a produção de uma imunoglobulina (Ig) específica para destruir o agente invasor. (As fotografias foram tiradas do Google).
As substâncias simples como: – Teflon, náilon, íons Fe, Au, Ti, etc. não funcionam como antígenos.
LINFÓCITOS.
Os linfócitos são as segundas células nas respostas imunológicas nos tecidos, pois sofrem diretamente as ações do superantígeno (interleucina 1) liberados pelos macrófagos.
Assim na vida extrauterina os linfócitos podem passar pelo Timo que é um órgão primário e estes linfócitos são os LINFÓCITOS T (LT).
Nas aves temos a BURSA, no homem existem os órgãos análogos como as Placas de Payer, amígdalas e apêndice cecal, e os linfócitos que por aí passam são os LINFÓCITOS B, (LB).
A grande maioria dos linfócitos não têm marcação e são chamados de linfócitos virgens.
Histodiferenciação dos linfócitos B.= L.B. + Superantígenos= Mitoses, L. Sensibilizados, L. Não sensibilizados, PLASMÓCITOS, que irá produzir as imunoglobulinas Ig.
As principais imunoglobulinas, produzidas são: – IgG, IgA, IgM, IgD e IgE.
A reação mediada pelas imunoglobulinas são chamadas de REAÇÃO HUMORAL, Ag X Ig.
Existem quadro tipos de reações:
Antígeno (Ag) X Anticorpo (Ig).
| Imunoglobulina envolvida | IgE + mastócitos. |
| Substâncias liberadas | Histamina; heparina; serotonina |
A HISTAMINA que provocará: Vaso dilatação, permeabilidade vascular, ação musculatura lisa, estímulo glândulas mucoides.
A HEPARINA: Substância anticoagulante.
A SEROTONINA: Ação musculatura lisa.
A alergia e a sensibilidade não têm diferença, o anticorpo é igual IgE. A diferença está na atopia, isto é, no local da reação.
As imunoglobulinas envolvidas: IgG e IgM + Membrana celular.
O antígeno aderido à célula que é o elemento afetado. Ocorre a reação de fixação do Complemento, com as reações em cascata, ocorrendo as Reações Imunológicas.
O local das reações são as membras das células bacterianas, viróticas ou outras.
Os antígenos (Ag), serão bactérias, vírus, pedaços de bactérias, que serão fagocitados pelos macrófagos, que produzirão o superantígeno, este atuará no plasmócito, que produzirão as imunoglobulinas IgG e IgM. Destas reações serão lançadas, a partir dos lisossomos, as seguintes enzimas de defesa: Fosfatase ácida ou alcalina, Fosfolipase, Hialuronidase, Colagenase, Aminopepidase, Elastase, Catepsina e peroxidase.
Estas substâncias irão atuar em toda área destruindo substância fundamental, fibras, vírus e células.
Como consequência desta reação poderá haver isquemia e necrose na área.
Algumas enfermidades causadas pelos complexos de Arthus: Artrite, Nefrite, Lúpus Eritematoso Sistêmico, vasculite, entre outras.
4. REAÇÃO DE FIXAÇÃO DO COMPLEMENTO.

Este tubo de ensaio mostra, os elementos figurados do sangue, primeiro os glóbulos vermelhos, depois os brancos, estes são os elementos figurados do sangue. Depois a parte líquida o soro.

Citocinas: São polipeptídios ou glicoproteínas produzidas por diversos tipos celulares e capazes de modular a resposta celular de diversas células, incluindo dela própria. Interleucinas: importante grupo das citocinas.
REAÇÕES IMUNOBIOLÓGICAS = PNN Polimorfos Nucleares Neutrófilos = necrose.
São reações de ativação do complemento ocorrem tanto “in vivo” como “in vitro”, o complemento é um conjunto de proteínas, que tem 9 elementos, totalizando 11 frações.
O complemento somente se fixa se houver reação antígeno X anticorpo, se não houver não haverá fixação de complemento.
Os anticorpos capazes de fixarem o complemento são: –
IgG e IgM.
Uma vez formado o complexo Ag X Ig as 9 proteínas e suas frações vão se fixar neste complexo, em uma reação em CASCATA.
C3 e o C3b continua com a reação em cascata.
O C9 a última etapa, é que se fixa à célula ou ao antígeno lizando a célula.
As bactérias gram-negativas quando lizadas liberam endotoxinas que vão atuar em todas as células vizinhas dos tecidos, destruindo as células. No local onde houver fixação do complemento haverá NECROSE.
Ag + Ig= C1-Ca++, C4-Mg++, C2, C3—-C3a, C5 C5a, C6, C7, C8, C9——lise G-, endotoxinas.
Se a bactéria for Gran+, no último complexo C9 ocorrerá a FAGOCITOSE por MACRÓFAGOS e PNN.
LINFÓCITO T. Os linfócitos T ativados têm 5 funções:
1. Eles são efetivos contra fungos, vírus e algumas infecções bacterianas, especialmente parasitas intracelulares como Mycobacterium.
2. Matam especificamente as células infectadas por vírus. Eles ajudam com a interleucina-2, os linfócitos B e T a responderem ao antígeno. As interleucinas (do grego , entre células brancas) são proteínas principalmente produzidas por leucócitos (por linfócitos T, macrófagos e eosinófilos) cada uma com suas funções, sendo que a maioria delas está envolvida na ativação ou supressão do sistema imune e na indução de divisão de outras células. Também possuem função na memória e são usados como medicamento
5. Os linfócitos efetores citotóxicos T, suprimem especificamente a resposta de outros linfócitos B e T. O efetor citotóxico são os principais responsáveis no combate as infecções virais.
Linfócito T + superantígeno = mitoses de linfócitos T.
Este Linfócito + interleucina-1 produz vários tipos de linfócitos: L. sensibilizados, L. de memória, L. não sensibilizados, L. citotóxicos.
Os Linfócitos Supressores, reagindo com o antígeno (Ag) sensibilizante atinge os linfócitos T que se multiplicam formando linfócitos de memória.
Reação mediadas por células. Hipersensibilidade do tipo tardio. Produz vários tipos de Linfocinas, as principais:
FAM – Fator agregador e ativador de macrófagos, estas células ativadas, começam a se mobilizar para o local da inflamação.
FIM – Fator inibidor de migração de macrófago. Os macrófagos ativados e atraídos para o local da inflamação permanecem no lugar graças a esta linfocina.
FM – Fator mitogênico. Induz a blastogênese nos linfócitos normais.
FAO – Fator ativador de osteoclasto.
FQM – Fator quimiotático para macrófagos, linfócitos, e polimorfos nucleares neutrófilos.
FFM – Fator de fusão de macrófagos. Causam a união dos macrófagos.
FIP – Fator inibidor de proliferação – inibe a proliferação de células cultivadas.
FI – Fator inibidor, inibe a migração dos granulócitos para a área.
FAF – Fator anti-fungo, inibe o crescimento dos fungos “in vitro”
Leucotoxinas: – Matam uma grande variedade de células cultivadas, são toxinas, geralmente bacterianas, que agem sobre os leucócitos (células de defesa do corpo) com o intuito de anular sua ação imunológica.
INTERFERON: Previne a multiplicação de vírus. O Interferon é uma proteína produzida pelos leucócitos e fibroblastos para interferir na replicação de fungos, vírus, bactérias e células de tumores e estimular a atividade de defesa de outras células.
Os linfócitos ativados com fatores mitogênicos ou antígenos, sintetizam e secretam uma grande família de moléculas conhecidas quimicamente como: – LINFOCINAS E INTERLEUCINAS.
INTERLEUCINA-1.
Produzida por macrófagos. É um fator mitogênico para linfócitos, e estimula o linfócito T a produzir a Interleucina-2 (IL-2) que é um fator importante na mitogênese dos linfócitos B.
INTERLEUCINA-2.
Muito importante na mitogênese dos linfócitos B.
Os macrófagos segregam além da interleucina, outras substâncias, como enzimas lisossomiais, protease neutra.
ANTICORPOS (Ig). São proteínas do tipo gama globulina, que pode ser abreviada por Ig. Os aspectos mais importantes dos anticorpos (Ig) são sua grande diversidade e a especifidade de suas respostas.
Os mecanismos que regulam as reações imunológicas são complexos e ainda não totalmente conhecidos.
Completando, os anticorpos (Ig), são glicoproteínas, também chamadas de imunoglobulinas, que possuem como principal função a defesa do organismo. Elas atuam de diferentes formas, para evitar que uma partícula invasora, vírus ou bactérias, causem danos à saúde.

Um anticorpo é tipicamente constituído por unidades estruturais básicas, cada uma das quais com duas grandes cadeias pesadas e duas cadeias leves de menor peso molecular. A molécula de anticorpo tem forma de Y; as extremidades dos braços do Y são o fragmento Fab por onde se ligam ao antígeno; o pé do Y é o fragmento Fc. As moléculas dos anticorpos podem aparecer em separado, como monómeros, ou associarem-se entre si formando dímeros com duas unidades ou pentâmeros com cinco unidades. Os anticorpos são sintetizados por um tipo de leucócito denominado linfócito B ou célula B.
A produção de anticorpos pelos plasmócitos é regulada pelos linfócitos “helper” e supressor.
MACRÓFAGO + ANTÍGENO = INTERLEUCINA – 1.
INTERLEUCINA-1 + LINFÓCITOS = LINFÓCITOS ATIVADOS
LIFÓCITO T ATIVADO “HELPER” produz = INTERLEUCINA-2, LINFOCINAS.
LINFOCINA – 1 E 2 + LINFÓCITO B = PRODUZ PLASMÓCITOS.
Existem 5 classes de anticorpos: IgG, IgA, IgM, IgD, IgE.
A RESPOSTA IMUNE PODE SER:
DIFERENTES MANIFESTAÇÕES DAS REAÇÕES ANTÍGENO & ANTICORPO.
AGLUTINAÇÃO. O antígeno Ag é sólido, partículas.
PRECIPITAÇÃO. O antígeno Ag é líquido solúvel.
NEUTRALIZAÇÃO. O antígeno é uma toxina.
FIXAÇÃO DO COMPLEMENTO. Ag + Ig + Complemento.
O complexo imune (Ig + Ag) participa ou induz um grande número de reações nos tecidos alterados patologicamente, tais como:
1. Reações do COMPLEMENTO.
2. Converte o plasminogênio em plasmina, com alteração do fibrinogênio e diretamente a quinina em quininogênio, estimulando a inflamação.
3. A ingestão do processo imune pelos fagócitos estimula esses a produzirem e liberarem a calicreina e outras enzimas hidrolíticas.
4. O complexo Ag + Ig na superfície dos mastócitos causarão sua degranulação causando reações de anafilaxia, pois liberam a histamina, e outras potentes substâncias vasoativas que provocam a inflamação, a heparina que podem provocar a reabsorção óssea e a protease, que podem participar da matéria celular.
REAÇÕES DO COMPLEMENTO.
A reação do complemento pode ser via clássica ou via alternativa.
O complemento consiste em uma grande família de proteínas, que corresponde a 10% das seroglobulinas do organismo. Quando ativadas por complexos imune, substâncias microbianas (Ag), ou por uma grande variedade de enzimas, as proteínas se interagem em reações em cascata, dando origem a uma grande variedade de substâncias biologicamente ativas que terminam destruindo e lisando as células.
IgG ou IgM, mais o Antígeno (Ag) específico, ativa o complemento.
Via clássica:
C1 – Complexo imune – C1 – C2 – – C 5,6,7,8,9 – LISE CELULAR.
Via alternativa: –
C3b – C3b – C3Bb – C5. 6, 7,..C9 – LISE CELULAR.
O Sistema Complemento, que pode ser considerado um amplificador do sistema imunológico, participa da resposta do hospedeiro a qualquer tipo de mudança patológica nos tecidos.
A opsonização é um fato importante na defesa do hospedeiro. O componente C3b tem duas opsoninas. As proteínas do complemento podem matar células também, mesmo na ausência de fagócitos.
As bactérias gram positivas podem ativar via alternativa do complemento, de forma efetiva.
As bactérias gram negativas ativam o complemento pela via clássica.
As principais reações atribuídas a ação do complemento incluem:
– Quimiotaxia para PMN. Aumento da permeabilidade vascular. Anafilatoxia. Aderência imunológica. Opsonização – aumento da fagocitose e da lize bacteriana.
Fator Hageman:- (FH), é liberado imediatamente após a injúria dos tecidos, inicia-se a reação em cascata e a conversão de plasminogênio em plasmina, produção de fibrinólise nos tecidos, mas ativa C3b, ativando o complemento por via alternativa.
A ativação do complemento representa um fato importante e fundamental em todas as formas de inflamações.
CONCLUSÕES:
Não resta dúvida que fenômenos imunológicos estão presentes em todas patologias.
Em um processo inflamatório nos tecidos conjuntivos, ocorre as seguintes inflamações específicas: Reações anafiláticas localizada. Reações citotóxicas. Reações de Arthus. Reações de fixação do complemento.
Depois temos os fenômenos ligados à imunidade celular-hipersensibilidade do tipo tardio – relacionada com os linfócitos T.
Consequências patológicas da reação imune: –
Apesar da reação imune ser inquestionavelmente benéfica ao hospedeiro, algumas reações patológicas podem ocorrer em certas circunstâncias, provocando efeitos deletérios ao hospedeiro. No caso da boca a perda dos dentes, por processo inflamatório, por efeito do (FAO), fator ativador de osteoclasto.
Assim certos componentes imunológicos se voltam contra os tecidos onde as reações se processam.
As reações onde os anticorpos (Ig), estão no plasma, ou dissolvidos no líquido intersticial, provocam reações imunes mais rápidas e são chamadas de hipersensibilidade imediata, associada a reações alérgicas.
Quando as reações imunes são mediadas por células, demoram mais, requerendo 48 a 72 horas ou mais, são descritas como hipersensibilidade aumentada.
Concluindo: Não resta dúvidas da complexidade que é o Sistema de Defesa do organismo humano.
Sua eficiência é inquestionável, pois diuturnamente ele nos defende de inúmeros agentes patológicos.
A memória das células, como os linfócitos T e dos macrófagos é ilimitada. Guiam os plasmócitos a produzirem imunoglobulinas específicas, destruindo de imediato uma centena de tipos de patógenos, e todo tipo de substâncias que penetram em nosso sistema.
Quando um vírus desconhecido, e altamente contagioso como o SARS-Cov-2, consegue passar pelo Sistema Imune, temos uma Pandemia catastrófica com a que vivemos.
Contudo a ciência é incansável, e dois tipos de Vacinas já estão descobertas, para estimular o sistema imune a produzir as imunoglobulinas que irão destruir o vírus invasor.
BIOLOGIA DA RESPOSTA IMUNOLÓGICA.
COVID 19.
Prof. Dr. Sérgio N. M. Lima.
Profa. Dra. Izabel Yoko Ito.
INTRODUÇÃO: Uma resposta imunológica é a reação do sistema imunológico a um antígeno. O processo de defesa do corpo através do sistema imunológico é chamado de resposta imune.
As respostas imunes sempre estão associadas a reações inflamatórias que foram uma grande preocupação para a saúde da população. Hoje, em virtude da Pandemia do Corona vírus, a doença ganhou, pela sua importância, um destaque em todo o mundo científico.
Os estudos da maioria das doenças, destes tempos antigos são relacionados ao processo inflamatório. Que o médico romano Celso anos 50dc, estudou profundamente a inflamação e, descreveu com precisão os sinais da inflamação, que são válidos até hoje: Edema, calor, rubor, dor e perda da função.
Este estudo tem por objetivo descrever, os complexos mecanismos envolvidos no processo inflamatório.
O Sistema de Defesa do organismo é complexo, mas perfeito em seus mecanismos.
Nossas pesquisas e estudos, na Faculdade de Odontologia e Farmácia da USP, foram mais relacionado a boca, contudo seus resultados se aplicam, na Biologia da Resposta Imunológica tem todo o corpo humano.
Para entendermos estas complexas reações estudaremos o Processo Inflamatório.
As reações inflamatórias, são mecanismos altamente diferenciados, as respostas do processo de defesa do organismo podem ser natas, isso é inespecífica, ou específicas.
A reposta inespecífica, são mediadas principalmente pelos neutrófilos, que têm a capacidade de fagocitarem e destruírem os patógenos (Ag).
NEUTRÓFILOS: São células sanguíneas leucocitárias que fazem parte essencial do sistema inato. Pertencem a classe dos granulócitos, junto aos eosinófilos e basófilos, pois apresentam núcleos lobulares e contêm grânulos citoplasmáticos. Estão envolvidos na defesa contra bactérias, fungos, vírus e partículas.
Contatos
Rua Visconde de Inhaúma, 590 – conjunto 205. CEP: 14010-100
Localização
Copyright © 2024 | Clínica Sérgio Lima – Todos os direitos reservados